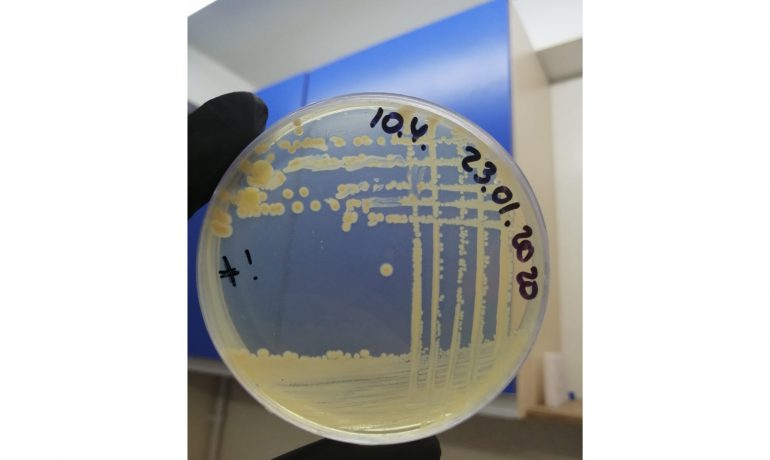
Відкриття науковиць НАНЦ
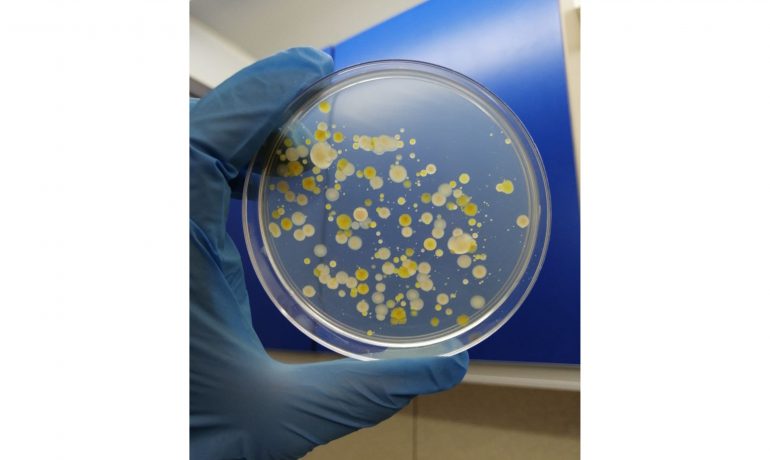
Відкриття науковиць НАНЦ

Вчені наблизилися до розгадки таємниці, як квітковим рослинам Антарктики вдається виживати в екстремальних умовах.
Йдеться про проєкт «Дослідження ролі ендофітних бактерій у підвищенні адаптивності антарктичних судинних рослин», яким керувала українська біологиня і полярниця Євгенія Прекрасна за підтримки EURIZON Fellowship.
Нагадуємо, що в Антарктиці є два види квіткових (судинних) рослин: щучник антарктичний і перлинниця. Вони виживають та поширюються в умовах низьких температур і значного ультрафіолетового випромінювання.
Вчених зацікавило, як рослинам у цьому допомагають бактерії, що мешкають всередині них.
Науковці визначили набори генетичної інформації (геноми) деяких таких симбіотичних антарктичних бактерій і виявили гени, які сприяють зменшенню стресу, синтезу фітогормонів, а також покращенню живлення рослин.
«Нам вдалось з’ясувати, що часто ці симбіотичні бактерії покращують стан рослин за нижчих, більш стресових температур. За деяких умов бактерії активізували гени, що сприяють росту рослин (наприклад, синтезу трегалози чи триптофану), безпосередньо всередині рослин», — зазначила Євгенія.
Більше того, бактерії впливають на кількість вторинних метаболітів всередині рослин (наприклад, фенолів, флавоноїдів чи глікозидів), які мають антиоксидантну функцію і так допомагають рослині долати стрес.
Також було встановлено, що деякі симбіотичні бактерії впливають на функціонування фотосинтетичного апарату рослин.
Це дослідження під керівництвом вченої НАНЦ зробило наукову спільноту ближчою до відкриття «суперсили» антарктичних рослин, яку в майбутньому можна буде використовувати на користь людства.
Проєкт впроваджувався Національним антарктичним науковим центром спільно з Національним ботанічним садом імені М. М. Гришка НАН України та лабораторією фотосинтетичних процесів, кафедра експериментальної біології рослин, Університет ім. Масарика (Брно, Чеська Республіка).